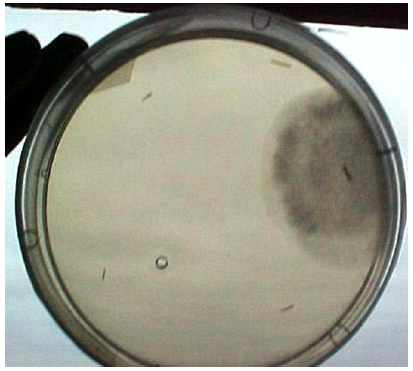

Esta obra está bajo una Licencia Creative Commons Atribución-NoComercial-SinDerivar 4.0 Internacional.
Recepción: 02 Noviembre 2015
Aprobación: 01 Junio 2016
Resumen: La enseñanza del método científico se ve facilitada mediante prácticas experimentales sencillas pero rigurosas. Los postulados de Koch representan un avance histórico en el desarrollo del método científico. Éstos constituyen una guía o protocolo a seguir para comprobar empíricamente que un determinado microorganismo es el agente causal de una patología infecciosa en un hospedero susceptible. En el presente trabajo se demuestra que la patología de marchitamiento fúngico (damping-off ) en plántulas de lechuga constituye un modelo didáctico-experimental para la enseñanza y la puesta en acción de dichos postulados. Fue posible la utilización de materiales de bajo costo con una metodología sencilla, reproducible y libre de riesgos para la salud humana, facilitando su aplicabilidad en cualquier centro de enseñanza secundaria o terciaria.
Palabras clave: Postulados de Koch, Método científico, Didáctica de la Microbiología, Marchitamiento fúngico, Pythium.
Abstract: The teaching of the scientific method is facilitated by simple but rigorous experimental practices. Koch's postulates represent a historical breakthrough in the development of the scientific method. These postulates are a guide or protocol to follow in order to find empirically that a particular microorganism is the causative agent of an infectious disease in a susceptible organism. The present work shows that the pathology of lettuce seedlings damping-off is an appropriate experimental model to teach these principles. It was possible to use low-cost materials with a simple, reproducible and free risk to human health methodology, with easy applicability in any high school or university classroom.
Keywords: Koch’s postulates, Scientific method, Microbiology teaching methods, Damping-off, Pythium.
Introducción
Los postulados desarrollados por Koch en 1882, representan un punto de inflexión en el desarrollo histórico de la Microbiología como una ciencia empírica. Éstos delimitan el marco adecuado para la elaboración de un protocolo experimental que permite demostrar que un microorganismo dado, es el agente causal de una determinada enfermedad infecciosa en un organismo hospedero susceptible (Volcy 2008).
En cualquier texto de Microbiología, como por ejemplo en Brock Biology of the Microorganism (Madigan et al. 2010), encontramos descritos los postulados de la siguiente manera:
- 1. El agente causal de la enfermedad o patógeno debe estar siempre presente en los organismos hospederos enfermos y ausente en los sanos.
- 2. El patógeno debe aislarse y multiplicarse in vitro en cultivo axénico, a partir del hospedero enfermo.
- 3. El patógeno aislado, debe provocar la misma enfermedad cuando es inoculado en hospederos sanos susceptibles.
- 4. El patógeno debe reaislarse a partir de los hospederos que fueron inoculados, obtenerse nuevamente un cultivo axénico de éste, presentando las mismas características observadas en el aislamiento original.
La lógica de éstos postulados puede aplicarse para el diseño experimental de ensayos en cualquier disciplina científica, ya que en ellos aparecen implícitos la utilización de lo que los investigadores en la actualidad denominan «controles» o «testigos». Éstos deben considerarse siempre para contrastar los posibles efectos de un determinado «tratamiento» y de esa forma validar o rechazar hipótesis. En el primer postulado, los hospederos sanos son considerados como el «control negativo» del experimento, ya que a partir de ellos no es posible aislar al patógeno. Una vez obtenido un aislamiento de individuos enfermos y luego de una multiplicación in vitro, se pondrá a prueba su patogenicidad a través de un «tratamiento» de inoculación en nuevos hospederos, que deberá provocar la misma sintomatología y finalmente se tendrá que reaislar. Por lo tanto el desarrollo de una práctica experimental basada en los postulados de Koch representaría una herramienta útil para la enseñanza del método científico a estudiantes de nivel secundario y terciario.
Dadas las restricciones de experimentación con animales y patógenos que afectan a éstos, por cuestiones éticas y o de riesgo biológico (posibles zoonosis) para las personas, sería conve-niente la elección de una patología vegetal con microorganismos inocuos para el ser humano, que permitan la realización de una práctica experimental basada en los postulados de Koch.
El marchitamiento fúngico (damping-off) es una enfermedad que sufren muchas especies vegetales en el estadio de plántulas, causado por diferentes agentes fúngicos que producen la destrucción de vasos de xilema próximos al sitio de infección, causando de esta forma un «estrangulamiento» en el tallo que conduce al marchitamiento y la «caída» de dichas plántulas (Agrios 2005), síntomas que son fácilmente observables a simple vista. Los agentes causales de ésta enfermedad pueden ser varias especies de hongos (Agrios 2005, Robledo et al. 2010, Diaz-Celaya et al. 2011), como por ejemplo Rhizoctonia sp. Fusarium sp. y otros microorganismos filamentosos con apariencia fúngica, que en la actualidad se encuentran clasificados dentro del Reino Stramenipila (Dick 2001, Lévesque 2011) y pertenecientes al Phyllum Oomycota como son los géneros Pythium sp. y Phytophthora sp. Los agentes causales más frecuentes de marchitamiento fúngico son especies pertenecientes al género Pythium, habiéndose aislado más de 120 especies con amplia distribución en todo el mundo (Diaz-Celaya et al. 2011). La identificación de las especies de dicho género se basa en características morfológicas de las estructuras reproductivas asexuales y principalmente sexuales llamadas oogonios y anteridios (femenina y masculina respectivamente) ambas observables con utilización de microscopía óptica (van der Plaats-Niterink 1981).
El objetivo del presente trabajo es el desarrollo de una actividad experimental, que mediante la utilización de una metodología sencilla y fácilmente reproducible, permita a los alumnos la puesta en práctica del método científico contenido en los postulados de Koch, utilizando como modelo una patología vegetal causada por agentes microbiológicos inocuos para la salud humana, como lo son agentes causales de marchitamiento fúngico en plántulas de lechuga (Lactuca sativa). El alumnado además de adquirir competencias en metodología de investigación, también podrá adquirir competencias en técnicas microbiológicas como: preparación de medio de cultivo, uso de instrumentos de esterilización de materiales, aislamiento de microorganismos, técnicas de asepsia, identificación de estructuras al microscopio óptico, entre otras.
Materiales, métodos y resultados
Medios de cultivo
Se utilizó el medio PDA (potato dextrose agar) para el aislamiento y propagación del patógeno. Se preparó tal como se describe a continuación (Ames 2004).
Se hace hervir en un litro de agua destilada, 200 gramos de papa sin pelar durante 20 minutos. La infusión obtenida se cuela y se le agregan 10 gramos de dextrosa (glucosa en polvo) y 18 gramos de agar, se esteriliza utilizando autoclave a 121 ºC a 15 atmósferas de presión durante 15 minutos.
En la figura 1 se muestra el modelo de autoclave utilizado en el presente trabajo. En el caso de no contar con autoclave, es posible la utilización de una olla de presión colocando en su interior una gradilla que permita poner poner sobre ella los medios en contenedores de vidrio para que no estén en contacto directo con el agua caliente, y se esterilicen por vapor.

Figura 1.
Se ha utilizado el autoclave All American modelo 50X.
Para que el patógeno aislado en el presente trabajo desarrollara sus estructuras reproductivas y de esta forma poder identificarlo con microscopía óptica, se utilizó el medio agar-agua, mezclando 10 gramos de agar por litro de agua destilada y realizando el mismo procedimiento de esterilización.
Preparación de placas de petri con medios de cultivo
Posterior a la esterilización, el medio PDA y agar-agua fueron dispensados en placas de petri plásticas de 100 mm x 15 mm esterilizadas en fábrica, trabajando de forma aséptica bajo mechero para evitar la caída de esporas contaminantes dentro de la placa con el medio vertido. Antes de utilizar las placas con los medios, éstas fueron almacenadas en estufa a temperatura de 20ºC durante siete días, con la finalidad de eliminar el exceso de humedad y comprobar la esterilidad de las mismas.
Aislamiento del agente causal (cumplimiento de los postulados números 1 y 2)
Se sembraron semillas de lechuga en un contenedor plástico con suelo colectado del ambiente, manteniendo la humedad en un nivel elevado con un riego diario. Dichas condiciones son las ideales para inducir la enfermedad de marchitamiento fúngico y, al cabo de diez días posteriores a la siembra, comenzaron a observarse plántulas enfermas.
Se colectaron ejemplares con y sin síntomas y se procedió con el siguiente protocolo.
Se cortaron los segmentos de raíces en trozos de 3 a 5 mm de longitud, se lavaron con agua de canilla para remover partículas de suelo y seguidamente con agua destilada. Posteriormente, se lavaron superficialmente con hipoclorito de sodio al 0,5 % durante 30 segundos, y en seguida se enjuagaron tres veces con agua destilada estéril, luego se secaron utilizando gasa estéril y finalmente se colocaron en placas de petri con medio PDA.
En la figura 2 se puede observar una foto de una placa de petri en donde se colocaron trozos de raíces de plántulas con síntomas y a partir de ellas emergieron hifas de un microorganismo filamentoso, de micelio blanquecino, y aspecto algodonoso.
Figura 2.
Aislamiento del posible agente causal de marchitamiento fúngico. Se observa el crecimiento a partir de trozo de plántula con síntomas.
A partir del trozo de plantas sanas, no se observó desarrollo de bacterias ni de otros microorganismos.
Mediante la técnica aséptica, se tomaron recortes con bisturí de los bordes de crecimiento del microorganismo emergido de los trozos vegetales y se le multiplicó en PDA y agar-agua. En este último medio creció de forma escasa y en la figura 3 se observa una fotografía tomada utilizando cámara de un smartphone colocada encima del ocular de un microscopio óptico a un aumento de 40X. En ésta fotografía se observa claramente un oogonio ornamentado con un único anteridio, confirmando que se trata de un aislamiento correspondiente al género Pythium. Las hifas se observaron cenocíticas (sin tabiques), lo cual es otra de las características del género.

Figura 3.
Fotografía de la estructura reproductiva sexual del aislamiento crecido en medio agar-agua. Oogonio con anteridio único.
Inducción de la patología utilizando el aislamiento (cumplimiento del postulado número 3); ensayo de germinación de plántulas
Para la comprobación de que el aislamiento obtenido es capaz de provocar la enfermedad, se siguió el siguiente protocolo.
Previamente para eliminar todos los microorganismos, se esterilizó en autoclave durante 45 minutos a 121 ºC a 1,5 atmósferas de presión, sustrato para almácigos en base a turba de Sphagnum finlandesa (Kekkila), utilizando bolsas de polipropileno termoresistentes (bolsas comerciales para asar pollos o pavos). Se separó la mitad del sustrato (250 gramos aproximadamente) esterilizado y se le inoculó el aislado mediante trozos de PDA de una placa con micelio en crecimiento durante 5 días a 20 ºC. Este sustrato, inoculado con el posible agente caudal, se incubó durante una semana a 20 ºC en oscuridad.
El sustrato inoculado y sin inocular fueron dispensados en contenedores plásticos y finalmente sembrados con semillas de lechuga.
En la figura 4 se observa el resultado del ensayo de germinación en sustrato inoculado y sin inóculo del aislado (control negativo). Como se puede visualizar, en el contenedor con inóculo, se tiene una zona con gran incidencia de la enfermedad, con varias plántulas presentando síntomas de marchitamiento fúngico. Por lo contrario en el control negativo, en dónde no se inoculó el aislado, no se observaron plántulas con dichos síntomas.

Figura 4.
(a) Resultado del ensayo de germinación en sustrato con y sin inóculo del aislado (derecha e izquierda respectivamente). (b) Detalle de la zona con incidencia de ataque y síntomas de marchitamiento fúngico en sustrato inoculado.
Reaislamiento del patógeno a partir de plántulas enfermas (cumplimiento del postulado número 4)
A partir de las plántulas enfermas se reaisló el patógeno, siguiendo el mismo procedimiento empleado para el cumplimiento de los postulados numero 1 y 2, observándose las mismas características ya descritas.
Discusión
En la mayoría de las publicaciones científicas que tratan sobre el aislamiento de fitopatógenos causantes de marchitamiento fúngico y otras patologías causadas por hongos, se detalla la utilización de medios específicos muy complejos de preparar (Montes-Belmont et al. 2003) o medios específicos más sencillos pero que incluyen el agregado de diversos antibióticos para el aislamiento de especies de Pythium (Diaz-Celaya et al. 2011). Dichos antibióticos pueden ser costosos y para un correcto uso se necesitan equipos e instrumentos de laboratorio más sofisticados y que en la mayoría de los centros educativos, especialmente los de nivel secundario no se cuenta, como por ejemplo: cámara de flujo laminar, balanzas de precisión, pipetas automáticas entre otros.
En el presente trabajo se utilizó un medio de fácil preparación como lo es el PDA, para el aislamiento y propagación del patógeno; medio que se obtiene a partir de ingredientes que se pueden conseguir fácilmente y de bajo costo. La identificación del género fue posible utilizando otro medio de cultivo sencillo, agar-agua, donde se desarrollaron estructuras reproductivas sexuales y asexuales propias de éste.
Se demostró que el aislamiento obtenido es un agente causal de marchitamiento fúngico, ya que cuando fue inoculado en sustrato previamente esterilizado por tratamiento térmico, provocó los síntomas en las plántulas crecidas en éste. Finalmente fue posible su reaislamiento presentando las mismas características morfológicas que en el aislamiento original, condición requerida para el cumplimiento del cuarto postulado.
Como se mencionó anteriormente, no solo diferentes especies de Pythium son capaces de provocar el marchitamiento fúngico (aunque su frecuencia de incidencia es mayor), otras especies de hongos pueden hacerlo y también es posible su aislamiento mediante ésta metodología empleada.
Por otra parte, si durante la fase de aislamiento, el paso de desinfección superficial de los trozos vegetales con hipoclorito de sodio no fue realizado adecuadamente, pueden crecer hongos u otros microorganismos saprófitos cuando sean colocados en medio PDA, obteniéndose falsos agentes causales. Es muy probable que crezcan hongos saprófitos no patogénicos como por ejemplo Mucor sp. y cepas no patogénicas de Fusarium sp., entre otros.
Pero éstos contaminantes pueden resultar útiles para emplearse en un segundo «control negativo» en el ensayo de germinación, ya que al inocularse en sustrato estéril no son capaces de provocar la patología en las plántulas.
Conclusiones
En el presente trabajo se demostró que siguiendo un procedimiento sencillo y basado en los postulados de Koch, fue posible encontrar el agente causal de la patología de marchitamiento fúngico de lechuga, en este caso un microorganismo perteneciente al género Pythium. Los agentes causales de esta patología, como el aislado en este trabajo, no representan riesgos para la salud humana.
Ya que fue posible utilizar materiales corrientes y de bajo costo, se demostró que esta metodología es fácilmente reproducible.
Dados estos argumentos, se puede concluir que este trabajo puede utilizarse como un modelo didáctico para la enseñanza del método científico implícito en los postulados de Koch y es posible su aplicación en cualquier centro de enseñanza secundaria o terciaria.
Agradecimientos
El autor desea agradecer a Vanesa Alvez, Sofía Artus, Felipe Díaz, Lucía de León, Nailea Ortega, Yaniré Ortega, Eloisa Salvarrey, Victoria Rivero y Daniel Veiga, quienes fueron sus alumnos de la asignatura Microbiología durante el año 2015 y mostraron un especial entusiasmo e interés por la realización de la práctica descrita en el presente trabajo.
Referencias
Agrios G. N. (2005) Plant Pathology. New York. Academic Press.
Ames de Icochea T. (2004) Manual de laboratorio para el manejo de hongos entomopatógenos. Lima. International Potato Center.
Diaz-Celaya M., Rodriguez-Alvarado G., Fernandez-Pavia S. P., Salgado-Garciglia R., SilvaRojas H. V., Pedraza-Santos M. E. (2011) Identificación de especies de Pythium aisladas de plantas ornamentales. Revista Mexicana de Ciencias Agrícolas Pub. Esp. Núm. 3, 431-443.
Dick M. W. (2001) p.67 en Straminipilous fungi. Systematics of the perenosporomyctes including accounts of the marine straminipilous protist, the plasmodiphorids and similar organisms. London. Kluwer Academic Publisher.
Lévesque C. A. (2011) Fifty years of oomycetes – From consolidation to evolutionary and genomic exploration. Fungal Diversity 50 (1), 35-46.
Madigan M. T., Martinko J. M., Clark D. P. (2010) Brock Biology of Microorganisms. Upper Saddle River, NJ. Pearson Prentice Hall.
Montes-Belmont R., Nava-Juárez R. A., Flores-Moctezuma H. E., Mundo-Ocampo M. (2003) Hongos y nematodos en raíces y bulbos de cebolla (Allium cepa L.) en el estado de Morelos, México. Revista Mexicana de Fitopatología 21, 300-303.
Robledo O., Etchebehere C., Lercari D. (2010) Relación entre la estructura de la comunidad bacteriana y la supresión al ahogamiento causado por Rhizoctonia solani en sustratos para plántulas de tomate. Avances en Investigación Agropecuaria 14 (2), 67-84.
van der Plaats-Niterink A. J. (1981) Monograph of the genus Pythium. Studies in Mycology 21, 1-244. Baarn. Centraalbureau voor Schimmelcultures.
Volcy C. (2008) Génesis y evolución de los postulados de Koch y su relación con la fitopatología. Una revisión. Agronomía Colombiana 26 (1), 107-115.
Información adicional
Para citar este artículo: Robledo D'Angelo O. (2016) Enfermedad de damping-off
en plántulas de lechuga: un modelo didáctico-experimental para la enseñanza de
los postulados de Koch. Revista Eureka sobre Enseñanza y Divulgación de las Ciencias 13 (3), 680-685. Recuperado de: http://hdl.handle.net/10498/18505
Enlace alternativo
http://revistas.uca.es/index.php/eureka/article/view/2998 (html)
